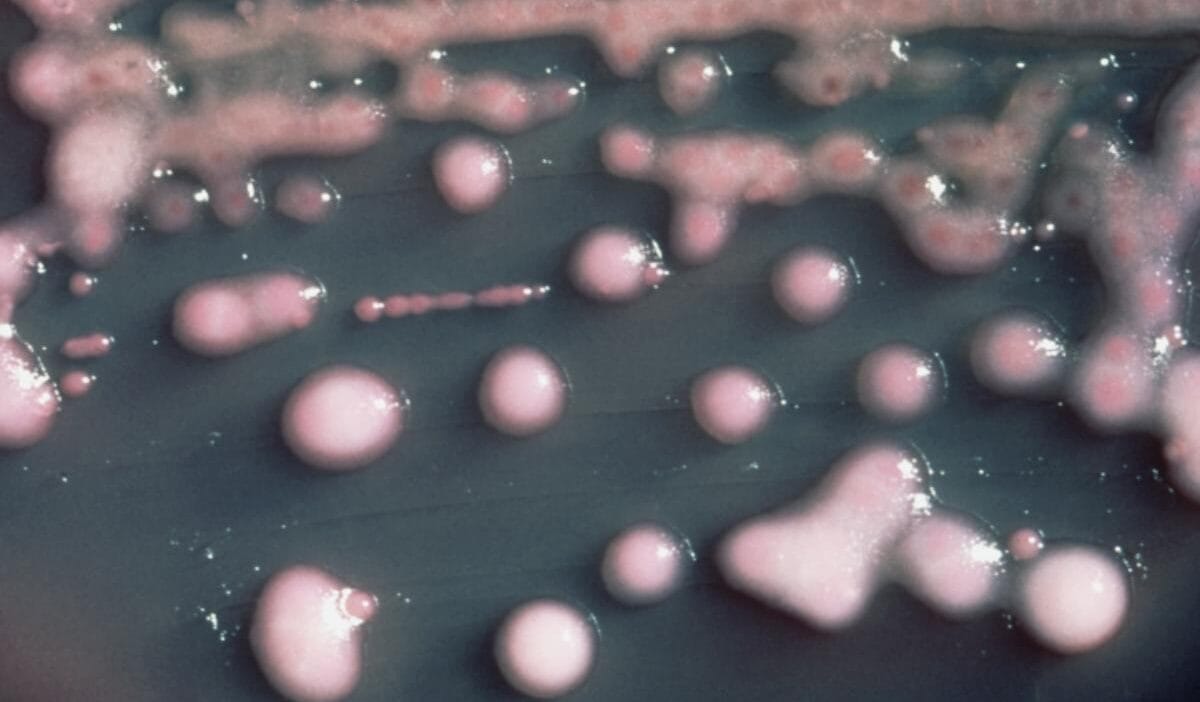
Kabus bocegi abd de hizla yayiliyor yuzde 460 artis ciddi bir tehdit 13117

Amerikalı bilim insanları, ABD’de NDM bakterisi enfeksiyonlarının sayısında artış olduğunu bildirdi. Uzmanlar, bu durumun halk sağlığı açısından ciddi bir tehdit oluşturduğunu açıkladı.
NDM Bakterisi: ABD’de Artan Feci Vaka Sayısı
Amerikan Hastalık Kontrol ve Önleme Merkezleri, 2019‑2023 döneminde NDM (New Delhi Metallo‑β‑Lactamase) enfeksiyonlarının ABD’de %460 artış gösterdiğini rapor etti. 2023’te 4.341 karbapenem‑dayanıklı bakteriyle enfeksiyon tespit edilmiştir; bunların 1.831’i NDM’ye aittir.
Uzmanların Uyarıları
Emory Üniversitesi’nden David Weiss, “NDM enfeksiyonlarının artışı ciddi bir tehdit oluşturuyor ve çok endişe verici” diye yorum yaptı. Araştırmacılar, birçok kişinin NDM taşıyıcıları olarak tanımlanmadığını ve birçok eyalette bu bakteri tespit edilememiş olduğunu belirtti.
COVID‑19 Pandemisi ile İlişki
Washington Üniversitesi’nde çalışan dr. Jason Burnham, pandemi sürecinde antimikotik kullanımının artmasının tedaviye karşı direnç gelişimine yol açtığını ifade etti. Bu durum, NDM gibi süper dirençli bakterilerin yayılmasını hızlandırabilir.
Poland’da NDM Vakaları
Polonya’da, 2021 Nisan ayında Ciechocink’te hoste edilmekte olan COVID‑19 hastalarında NDM keskin idrese geçirilmiştir. Üç hasta şüpheyle paralel bir bakteri tespiti alırken, bir kadın hayati.